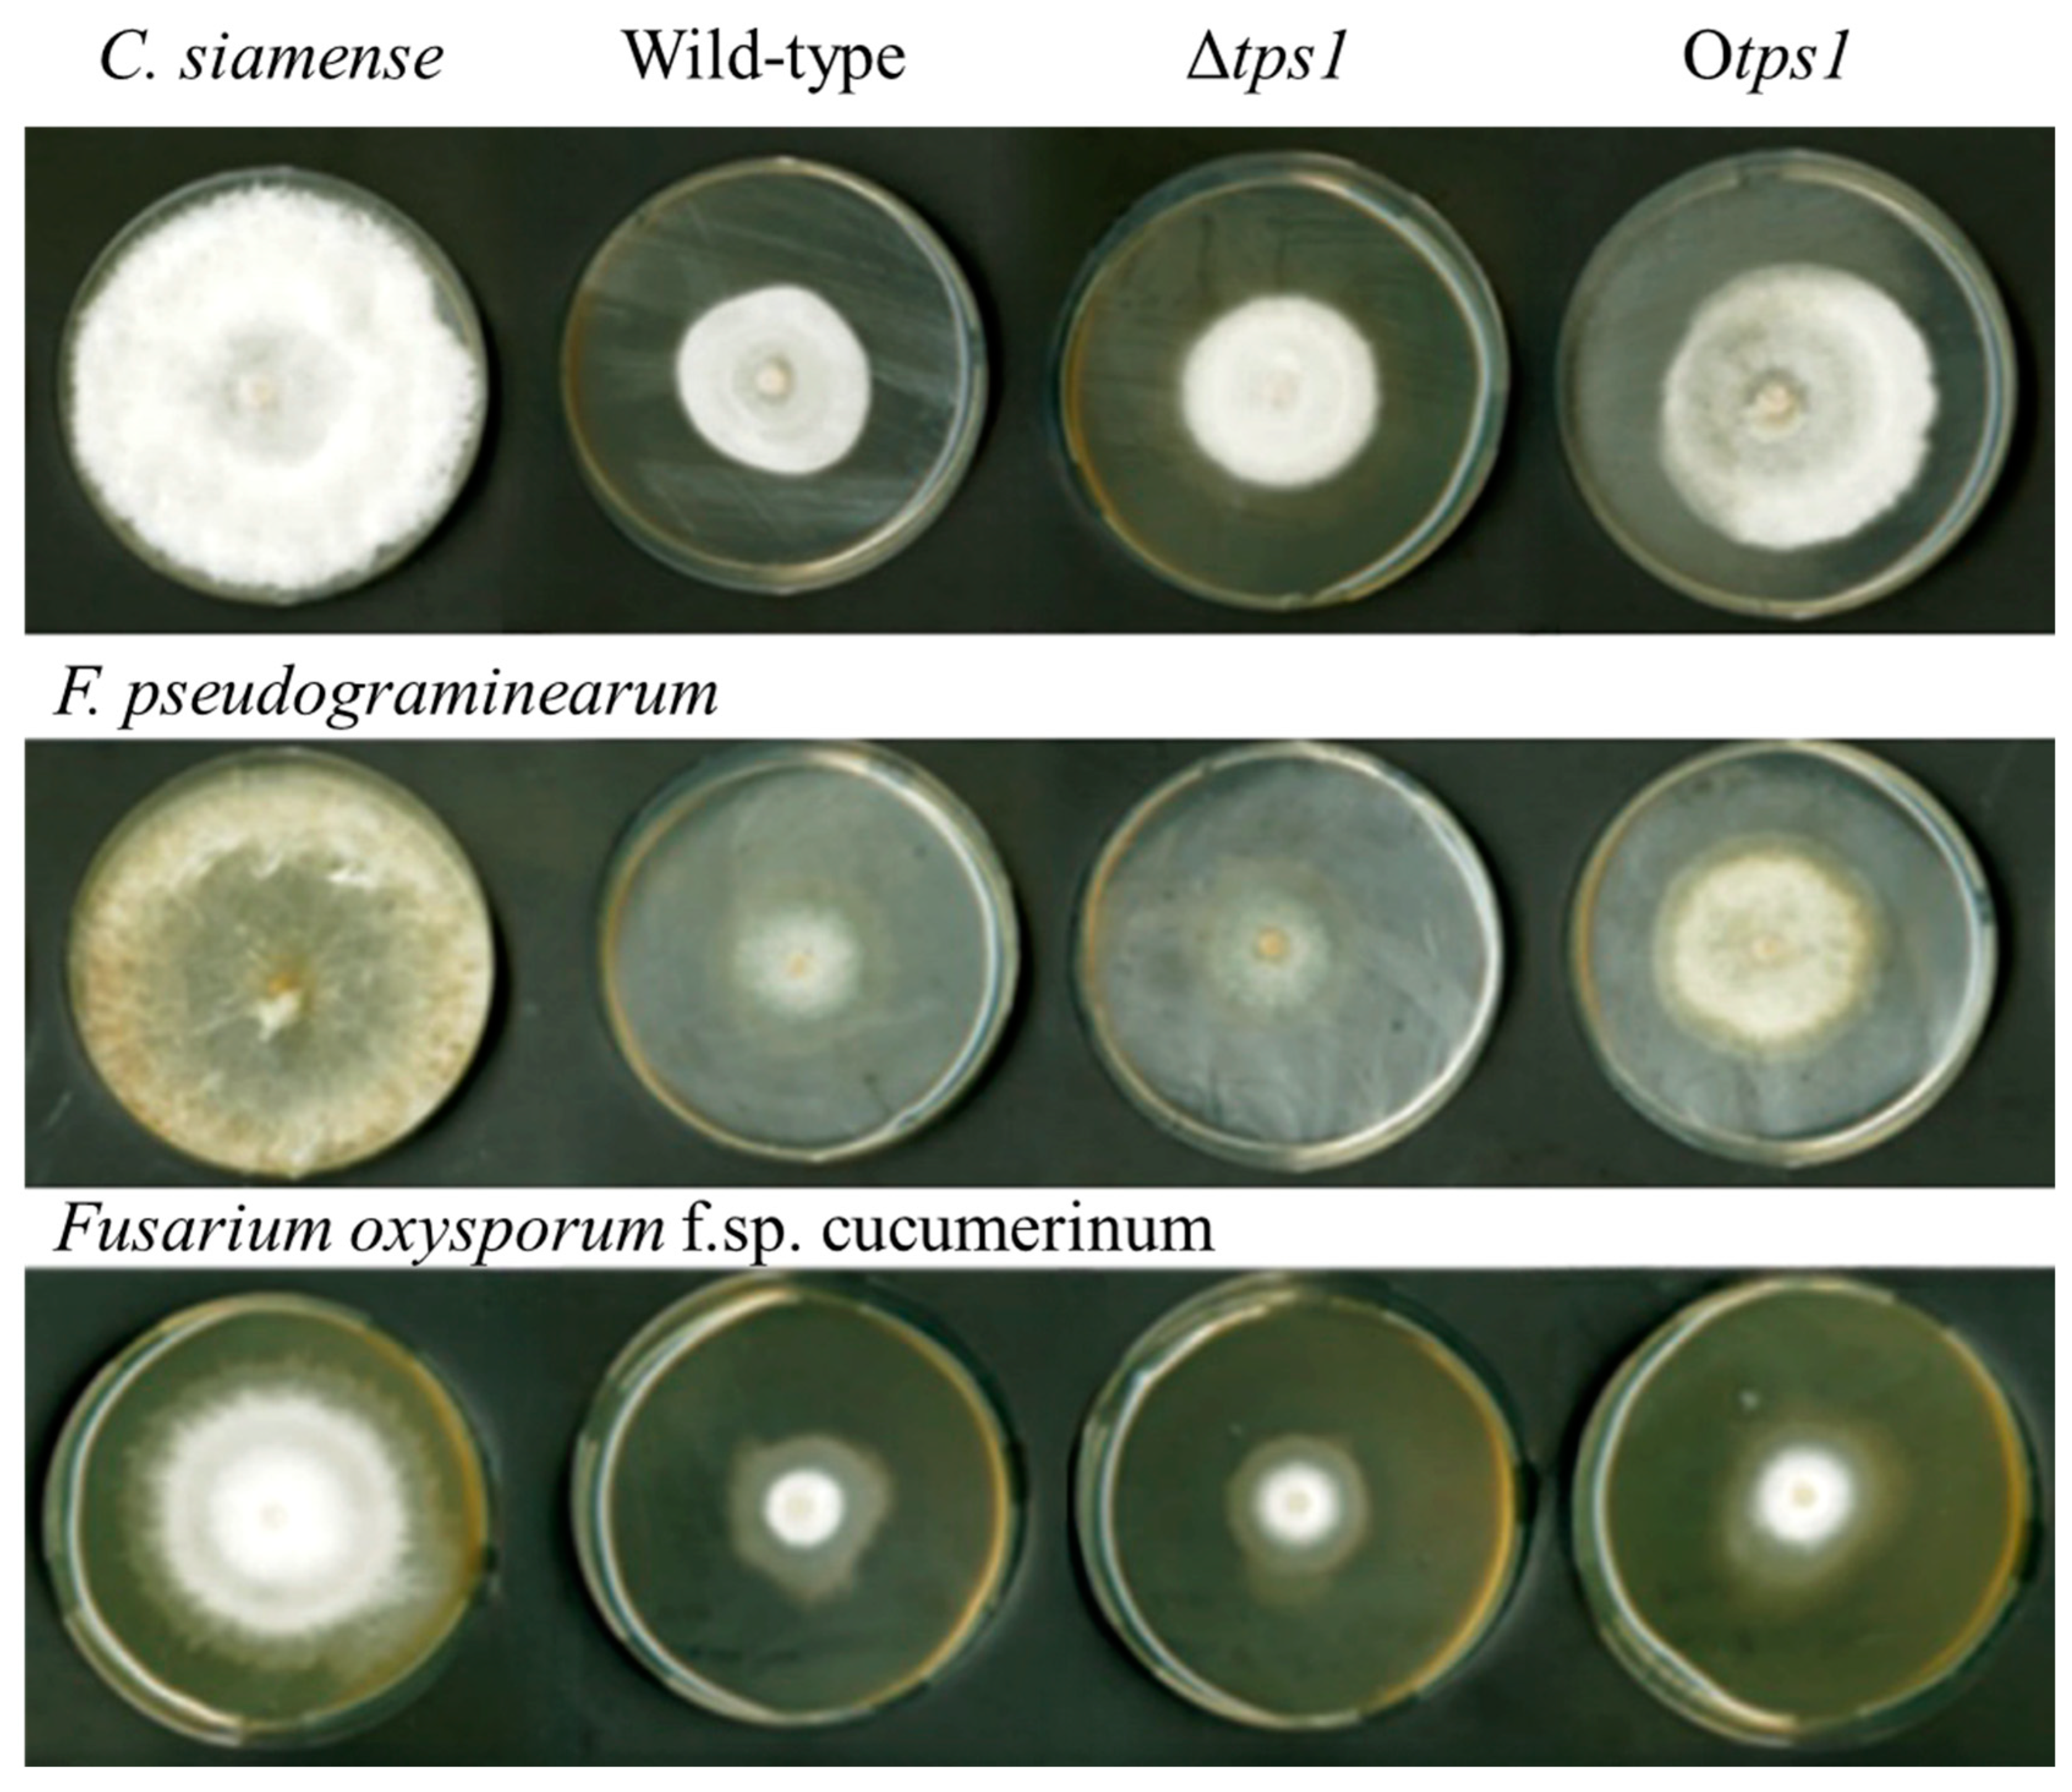
Jof 10 00485 g007

Impact of tps1 Deletion and Overexpression on Terpene Metabolites in Trichoderma atroviride
Abstract
1. Introduction
2. Materials and Methods
2.1. Strain, Medium, and Culture Conditions
2.2. tps1 Gene Cloning and Bioinformatic Analysis
2.3. Generation of tps1-Deletion and -Overexpression Transformants
2.4. Transformation of T. atroviride HB20111
2.5. Extraction of RNA and Evaluation of tps1 Gene Expression
2.6. Measurement of the Terpene Metabolites by Gas Chromatography–Mass Spectrometry (GC-MS)
2.7. Growth Assays of Transformants
2.8. Antagonistic Activity
2.9. Analysis of Growth-Related Traits in Wheat
2.10. Statistics
3. Results
3.1. Phylogenetic and Sequence Comparison
3.2. Generation of tps1 Deletion and Overexpression Transformants
3.3. GC-MS Analysis
3.4. Preliminary Phenotypic Analysis of Deletion and Overexpression Mutants
3.5. Preliminary Phenotypic Analysis of Deletion and Overexpression Mutants
3.6. Growth-Promoting Effect
4. Discussion
5. Conclusions
Supplementary Materials
Author Contributions
Funding
Institutional Review Board Statement
Informed Consent Statement
Data Availability Statement
Acknowledgments
Conflicts of Interest
References
- Dong, J.-Y.; Chen, Y.-G.; Song, H.-C.; Zhu, Y.-H.; Zhou, Y.-P.; Li, L.; He, Y.-P.; Cao, J.; Zhang, K.-Q. Hydroxylation of the Triterpenoid Nigranoic Acid by the Fungus Gliocladium Roseum YMF1.00133. Chem. Biodivers. 2007, 4, 112–117. [Google Scholar] [CrossRef] [PubMed]
- Sun, H.-D.; Liu, S.; Wang, Z.-Y.; Lin, Z. Nigranoic Acid, a Triterpenoid from Schisandra Sphaerandra That Inhibits HIV-1 Reverse Transcriptase. J. Nat. Prod. 1996, 59, 525–527. [Google Scholar] [CrossRef] [PubMed]
- Bureau, J.-A.; Oliva, M.E.; Dong, Y.; Ignea, C. Engineering Yeast for the Production of Plant Terpenoids Using Synthetic Biology Approaches. Nat. Prod. Rep. 2023, 40, 1822–1848. [Google Scholar] [CrossRef]
- Keasling, J.D. Synthetic Biology and the Development of Tools for Metabolic Engineering. Metab. Eng. 2012, 14, 189–195. [Google Scholar] [CrossRef]
- Larkin, M.A.; Blackshields, G.; Brown, N.P.; Chenna, R.; McGettigan, P.A.; McWilliam, H.; Valentin, F.; Wallace, I.M.; Wilm, A.; Lopez, R.; et al. Clustal W and Clustal X Version 2.0. Bioinforma. Oxf. Engl. 2007, 23, 2947–2948. [Google Scholar] [CrossRef] [PubMed]
- Yin, Z.; Dickschat, J.S. Engineering Fungal Terpene Biosynthesis. Nat. Prod. Rep. 2023, 40, 28–45. [Google Scholar] [CrossRef]
- Cox, R.J.; Gulder, T.A.M. Introduction to Engineering the Biosynthesis of Fungal Natural Products. Nat. Prod. Rep. 2023, 40, 7–8. [Google Scholar] [CrossRef]
- Kim, K.; Heo, Y.M.; Jang, S.; Lee, H.; Kwon, S.-L. Diversity of Trichoderma Spp. in Marine Environments and Their Biological Potential for Sustainable Industrial Applications. Sustainability 2020, 12, 4327. [Google Scholar] [CrossRef]
- Bai, B.; Liu, C.; Zhang, C.; He, X.; Wang, H.; Peng, W.; Zheng, C. Trichoderma Species from Plant and Soil: An Excellent Resource for Biosynthesis of Terpenoids with Versatile Bioactivities. J. Adv. Res. 2023, 49, 81–102. [Google Scholar] [CrossRef]
- Contreras-Cornejo, H.A.; Macías-Rodríguez, L.; del-Val, E.; Larsen, J. Ecological Functions of Trichoderma Spp. and Their Secondary Metabolites in the Rhizosphere: Interactions with Plants. FEMS Microbiol. Ecol. 2016, 92, fiw036. [Google Scholar] [CrossRef]
- Lee, H.B.; Kim, Y.; Jin, H.Z.; Lee, J.J.; Kim, C.-J.; Park, J.Y.; Jung, H.S. A New Hypocrea Strain Producing Harzianum A Cytotoxic to Tumour Cell Lines. Lett. Appl. Microbiol. 2005, 40, 497–503. [Google Scholar] [CrossRef] [PubMed]
- Rukachaisirikul, V.; Chinpha, S.; Phongpaichit, S.; Saikhwan, N.; Sakayaroj, J.; Preedanon, S. Sesquiterpene and Monoterpene Derivatives from the Soil-Derived Fungus Trichoderma reesei PSU-SPSF013. Phytochem. Lett. 2019, 30, 124–129. [Google Scholar] [CrossRef]
- Rao, Y.; Zeng, L.; Jiang, H.; Mei, L.; Wang, Y. Trichoderma atroviride LZ42 Releases Volatile Organic Compounds Promoting Plant Growth and Suppressing Fusarium Wilt Disease in Tomato Seedlings. BMC Microbiol. 2022, 22, 88. [Google Scholar] [CrossRef] [PubMed]
- Li, W.-Y.; Liu, Y.; Lin, Y.-T.; Liu, Y.-C.; Guo, K.; Li, X.-N.; Luo, S.-H.; Li, S.-H. Antibacterial Harziane Diterpenoids from a Fungal Symbiont Trichoderma atroviride Isolated from Colquhounia coccinea Var. Mollis. Phytochemistry 2020, 170, 112198. [Google Scholar] [CrossRef] [PubMed]
- Tang, X.-X.; Liu, S.-Z.; Sun, Y.-Y.; He, F.-M.; Xu, G.-X.; Fang, M.-J.; Zhen, W.; Qiu, Y.-K. New Cyclopentenoneacrylic Acid Derivatives from a Marine-Derived Fungus Trichoderma atroviride H548. Nat. Prod. Res. 2021, 35, 3772–3779. [Google Scholar] [CrossRef] [PubMed]
- Adelin, E.; Servy, C.; Martin, M.-T.; Arcile, G.; Iorga, B.I.; Retailleau, P.; Bonfill, M.; Ouazzani, J. Bicyclic and Tetracyclic Diterpenes from a Trichoderma Symbiont of Taxus baccata. Phytochemistry 2014, 97, 55–61. [Google Scholar] [CrossRef]
- Yamamoto, T.; Izumi, N.; Ui, H.; Sueki, A.; Masuma, R.; Nonaka, K.; Hirose, T.; Sunazuka, T.; Nagai, T.; Yamada, H.; et al. Wickerols A and B: Novel Anti-Influenza Virus Diterpenes Produced by Trichoderma atroviride FKI-3849. Tetrahedron 2012, 68, 9267–9271. [Google Scholar] [CrossRef]
- Kong, Z.; Jing, R.; Wu, Y.; Guo, Y.; Geng, Y.; Ji, J.; Qin, L.; Zheng, C. Trichodermadiones A and B from the Solid Culture of Trichoderma atroviride S361, an Endophytic Fungus in Cephalotaxus fortunei. Fitoterapia 2018, 127, 362–366. [Google Scholar] [CrossRef]
- Zhou, P.; Wu, Z.; Tan, D.; Yang, J.; Zhou, Q.; Zeng, F.; Zhang, M.; Bie, Q.; Chen, C.; Xue, Y.; et al. Atrichodermones A-C, Three New Secondary Metabolites from the Solid Culture of an Endophytic Fungal Strain, Trichoderma atroviride. Fitoterapia 2017, 123, 18–22. [Google Scholar] [CrossRef]
- Jia, Q.; Brown, R.; Tobias, G.K.; Fu, J.; Chen, X. Origin and Early Evolution of the Plant Terpene Synthase Family. Proc. Natl. Acad. Sci. USA 2022, 119, e2100361119. [Google Scholar] [CrossRef]
- Keeling, C.I.; Weisshaar, S.; Lin, R.P.C.; Bohlmann, J. Functional Plasticity of Paralogous Diterpene Synthases Involved in Conifer Defense. Proc. Natl. Acad. Sci. USA 2008, 105, 1085–1090. [Google Scholar] [CrossRef] [PubMed]
- Vranová, E.; Coman, D.; Gruissem, W. Network Analysis of the MVA and MEP Pathways for Isoprenoid Synthesis. Annu. Rev. Plant Biol. 2013, 64, 665–700. [Google Scholar] [CrossRef] [PubMed]
- Lombard, J.; Moreira, D. Origins and Early Evolution of the Mevalonate Pathway of Isoprenoid Biosynthesis in the Three Domains of Life | Molecular Biology and Evolution|Oxford Academic. Mol. Biol. Evol. 2011, 28, 87–99. [Google Scholar] [CrossRef] [PubMed]
- Zeng, L.; Dehesh, K. The Eukaryotic MEP-Pathway Genes Are Evolutionarily Conserved and Originated from Chlaymidia and Cyanobacteria | BMC Genomics|Full Text. BMC Genomics 2021, 22, 137. [Google Scholar] [CrossRef] [PubMed]
- Christianson, D.W. Structural and Chemical Biology of Terpenoid Cyclases|Chemical Reviews. Chem. Rev. 2017, 117, 11570–11648. [Google Scholar] [CrossRef] [PubMed]
- Li, M.; Tao, H. Enhancing Structural Diversity of Terpenoids by Multisubstrate Terpene Synthases. Beilstein J. Org. Chem. 2024, 20, 959–972. [Google Scholar] [CrossRef] [PubMed]
- Sui, L.; Li, J.; Philp, J.; Yang, K.; Wei, Y.; Li, H.; Li, J.; Li, L.; Ryder, M.; Toh, R.; et al. Trichoderma atroviride Seed Dressing Influenced the Fungal Community and Pathogenic Fungi in the Wheat Rhizosphere. Sci. Rep. 2022, 12, 9677. [Google Scholar] [CrossRef] [PubMed]
- Tamura, K.; Stecher, G.; Kumar, S. MEGA11: Molecular Evolutionary Genetics Analysis Version 11. Mol. Biol. Evol. 2021, 38, 3022–3027. [Google Scholar] [CrossRef] [PubMed]
- Zhang, H.; Zhe, L.; Zheng, Z.; Wang, Q. Functional Analysis and Application of pH Response Factor-Encoding Gene TvPacC in Trichoderma viride. Sci. Technol. Eng. 2022, 22, 15959–15966. [Google Scholar]
- Brunner, K.; Omann, M.; Pucher, M.E.; Delic, M.; Lehner, S.M.; Domnanich, P.; Kratochwill, K.; Druzhinina, I.; Denk, D.; Zeilinger, S. Trichoderma G Protein-Coupled Receptors: Functional Characterisation of a cAMP Receptor-like Protein from Trichoderma atroviride. Curr. Genet. 2008, 54, 283–299. [Google Scholar] [CrossRef]
- Stoppacher, N.; Kluger, B.; Zeilinger, S.; Krska, R.; Schuhmacher, R. Identification and Profiling of Volatile Metabolites of the Biocontrol Fungus Trichoderma atroviride by HS-SPME-GC-MS. J. Microbiol. Methods 2010, 81, 187–193. [Google Scholar] [CrossRef]
- Yang, M.; Huang, C.; Xue, Y.; Li, S.; Lu, L.; Wang, C. Biofumigation with Volatile Organic Compounds from Streptomyces Alboflavus TD-1 and Pure Chemicals to Control Aspergillus Ochraceus—Yang—2018—Annals of Applied Biology—Wiley Online Library. Ann. Appl. 2018, 173, 313–322. [Google Scholar] [CrossRef]
- Arnon, D.I. Copper Enzymes in Isolated Chloroplasts. Polyphenoloxidase in Beta vulgaris. Plant Physiol. 1949, 24, 1–15. [Google Scholar] [CrossRef] [PubMed]
- Buysse, J.; Merckx, R. An Improved Colorimetric Method to Quantify Sugar Content of Plant Tissue. J. Exp. Bot. 1993, 44, 1627–1629. [Google Scholar] [CrossRef]
- López-Gallego, F.; Wawrzyn; Grayson, T.; Schmidt-Dannert, C. Selectivity of Fungal Sesquiterpene Synthases: Role of the Active Site’s H-1α Loop in Catalysis. Appl. Environ. Microbiol. 2010, 76, 7723–7733. [Google Scholar] [CrossRef] [PubMed][Green Version]
- Liu, X.; Qin, R.; Li, J.; Liao, S.; Shan, T.; Xu, R.; Wu, D.; Wei, P. A CRISPR-Cas9-Mediated Domain-Specific Base-Editing Screen Enables Functional Assessment of ACCase Variants in Rice. Plant Biotechnol. J. 2020, 18, 1845–1847. [Google Scholar] [CrossRef]
- Akiyama, K.; Matsuzaki, K.; Hayashi, H. Plant Sesquiterpenes Induce Hyphal Branching in Arbuscular Mycorrhizal Fungi. Nature 2005, 435, 824–827. [Google Scholar] [CrossRef] [PubMed]
- Huang, Y.; Liu, C.; Huo, X.; Lai, X.; Zhu, W.; Hao, Y.; Zheng, Z.; Guo, K. Enhanced Resistance to Heat and Fungal Infection in Transgenic Trichoderma via Over-Expressing the HSP70 Gene. AMB Express 2024, 14, 34. [Google Scholar] [CrossRef]
- Muchlinski, A.; Ibdah, M.; Ellison, S.; Yahyaa, M.; Nawade, B.; Laliberte, S.; Senalik, D.; Simon, P.; Whitehead, S.R.; Tholl, D. Diversity and Function of Terpene Synthases in the Production of Carrot Aroma and Flavor Compounds. Sci. Rep. 2020, 10, 9989. [Google Scholar] [CrossRef]
- Padovan, A.; Keszei, A.; Hassan, Y.; Krause, S.T.; Köllner, T.G.; Degenhardt, J.; Gershenzon, J.; Külheim, C.; Foley, W.J. Four Terpene Synthases Contribute to the Generation of Chemotypes in Tea Tree (Melaleuca alternifolia). BMC Plant Biol. 2017, 17, 160. [Google Scholar] [CrossRef]
- Yu, D.; Wang, J.; Shao, X.; Xu, F.; Wang, H. Antifungal Modes of Action of Tea Tree Oil and Its Two Characteristic Components against Botrytis cinerea. J. Appl. Microbiol. 2015, 119, 1253–1262. [Google Scholar] [CrossRef] [PubMed]
- Menezes, I.O.; Scherf, J.R.; Martins, A.O.B.P.B.; Ramos, A.G.B.; Quintans, J.d.S.S.; Coutinho, H.D.M.; Ribeiro-Filho, J.; de Menezes, I.R.A. Biological Properties of Terpinolene Evidenced by In Silico, In Vitro and In Vivo Studies: A Systematic Review. Phytomedicine 2021, 93, 153768. [Google Scholar] [CrossRef] [PubMed]
- Bonesi, M.; Menichini, F.; Tundis, R.; Loizzo, M.R.; Conforti, F.; Passalacqua, N.G.; Statti, G.A.; Menichini, F. Acetylcholinesterase and Butyrylcholinesterase Inhibitory Activity of Pinus Species Essential Oils and Their Constituents. J. Enzyme Inhib. Med. Chem. 2010, 25, 622–628. [Google Scholar] [CrossRef] [PubMed]
- Yusoff, N.; Abd Ghani, I.; Othman, N.W.; Aizat, W.M.; Hassan, M. Toxicity and Sublethal Effect of Farnesyl Acetate on Diamondback Moth, Plutella xylostella (L.) (Lepidoptera: Plutellidae). Insects 2021, 12, 109. [Google Scholar] [CrossRef] [PubMed]
- Annie Price, CHHC. 2018. 11 Essential Oils for Cellulite: Benefits & Uses. Available online: https://draxe.com/essential-oils/essential-oils-for-cellulite (accessed on 1 April 2023).
- Miller, D.R.; Borden, J.H. β-Phellandrene: Kairomone for Pine Engraver, Ips pini (Say) (Coleoptera: Scolytidae). J. Chem. Ecol. 1990, 16, 2519–2531. [Google Scholar] [CrossRef] [PubMed]
- Ioannou, Y.M.; Wilson, A.G.; Anderson, M.W. Effect of Butylated Hydroxyanisole, Alpha-Angelica Lactone, and Beta-Naphthoflavone on Benzo(Alpha)Pyrene:DNA Adduct Formation In Vivo in the Forestomach, Lung, and Liver of Mice. Cancer Res. 1982, 42, 1199–1204. [Google Scholar] [PubMed]
- Calva, J.; Bec, N.; Gilardoni, G.; Larroque, C.; Cartuche, L.; Bicchi, C.; Montesinos, J.V. Acorenone B: AChE and BChE Inhibitor as a Major Compound of the Essential Oil Distilled from the Ecuadorian Species Niphogeton dissecta (Benth.) J.F. Macbr. Pharm. Basel Switz. 2017, 10, 84. [Google Scholar] [CrossRef]
- Singh, S.; Chhatwal, H.; Pandey, A. Deciphering the Complexity of Terpenoid Biosynthesis and Its Multi-level Regulatory Mechanism in Plants. J. Plant Growth Regul. Published online May 14 2024, 1–17. [Google Scholar] [CrossRef]
- Chen, C.; Zheng, Y.; Zhong, Y.; Wu, Y.; Li, Z.; Xu, L.A.; Xu, M. Transcriptome analysis and identification of genes related to terpenoid biosynthesis in Cinnamomum camphora. BMC Genom. 2018, 19, 550. [Google Scholar] [CrossRef]
- Mehari, T.G.; Fang, H.; Feng, W.; Zhang, Y.; Umer, M.J.; Han, J.; Ditta, A.; Khan, M.K.R.; Liu, F.; Wang, K.; et al. Genome-wide identification and expression analysis of terpene synthases in Gossypium species in response to gossypol biosynthesis. Funct. Integr. Genom. 2023, 23, 197. [Google Scholar] [CrossRef]
- Liu, H.; Pu, Y.-H.; Ren, J.-W.; Li, E.-W.; Guo, L.-X.; Yin, W.-B. Genetic Dereplication Driven Discovery of a Tricinoloniol Acid Biosynthetic Pathway in Trichoderma hypoxylon. Org. Biomol. Chem. 2020, 18, 5344–5348. [Google Scholar] [CrossRef] [PubMed]
- Steele, C.L.; Crock, J.; Bohlmann, J.; Croteau, R. Sesquiterpene Synthases from Grand Fir (Abies grandis). Comparison of Constitutive and Wound-Induced Activities, and cDNA Isolation, Characterization, and Bacterial Expression of Delta-Selinene Synthase and Gamma-Humulene Synthase. J. Biol. Chem. 1998, 273, 2078–2089. [Google Scholar] [CrossRef] [PubMed]
- Vedula, L.S.; Rynkiewicz, M.J.; Pyun, H.-J.; Coates, R.M.; Cane, D.E.; Christianson, D.W. Molecular Recognition of the Substrate Diphosphate Group Governs Product Diversity in Trichodiene Synthase Mutants. Biochemistry 2005, 44, 6153–6163. [Google Scholar] [CrossRef]
- Champagne, D.E.; Koul, O.; Isman, M.B.; Scudder, G.G.E.; Neil Towers, G.H. Biological Activity of Limonoids from the Rutales. Phytochemistry 1992, 31, 377–394. [Google Scholar] [CrossRef]
- Shu, B.; Lin, Y.; Huang, Y.; Liu, L.; Cai, X.; Lin, J.; Zhang, J. Characterization and Transcriptomic Analyses of the Toxicity Induced by Toosendanin in Spodoptera frugipreda. Gene 2024, 893, 147928. [Google Scholar] [CrossRef]
- Kramer, R.; Abraham, W.-R. Volatile Sesquiterpenes from Fungi: What Are They Good For? Phytochem. Rev. 2012, 11, 15–37. [Google Scholar] [CrossRef]

| C. siamense | F. pseudograminearum | Fusarium oxysporum f.sp. cucumerinum | |
|---|---|---|---|
| WT | 34 ± 0.8185 b * | 48.367 ± 0.7506 c | 36.133 ± 2.7538 b |
| Δtps1 | 50.433 ± 0.611 a | 55.567 ± 1.35 a | 34.167 ± 4.7543 b |
| Otps1 | 27.8 ± 2.0811 c | 51 ± 0.2 b | 43.667 ± 2.3029 a |
Disclaimer/Publisher’s Note: The statements, opinions and data contained in all publications are solely those of the individual author(s) and contributor(s) and not of MDPI and/or the editor(s). MDPI and/or the editor(s) disclaim responsibility for any injury to people or property resulting from any ideas, methods, instructions or products referred to in the content. |
© 2024 by the authors. Licensee MDPI, Basel, Switzerland. This article is an open access article distributed under the terms and conditions of the Creative Commons Attribution (CC BY) license (https://creativecommons.org/licenses/by/4.0/).
Share and Cite
Wang, X.; Li, W.; Cui, S.; Wu, Y.; Wei, Y.; Li, J.; Hu, J. Impact of tps1 Deletion and Overexpression on Terpene Metabolites in Trichoderma atroviride. J. Fungi 2024, 10, 485. https://doi.org/10.3390/jof10070485
Wang X, Li W, Cui S, Wu Y, Wei Y, Li J, Hu J. Impact of tps1 Deletion and Overexpression on Terpene Metabolites in Trichoderma atroviride. Journal of Fungi. 2024; 10(7):485. https://doi.org/10.3390/jof10070485
Chicago/Turabian StyleWang, Xinyue, Wenzhe Li, Shuning Cui, Yuanzheng Wu, Yanli Wei, Jishun Li, and Jindong Hu. 2024. "Impact of tps1 Deletion and Overexpression on Terpene Metabolites in Trichoderma atroviride" Journal of Fungi 10, no. 7: 485. https://doi.org/10.3390/jof10070485
APA StyleWang, X., Li, W., Cui, S., Wu, Y., Wei, Y., Li, J., & Hu, J. (2024). Impact of tps1 Deletion and Overexpression on Terpene Metabolites in Trichoderma atroviride. Journal of Fungi, 10(7), 485. https://doi.org/10.3390/jof10070485

